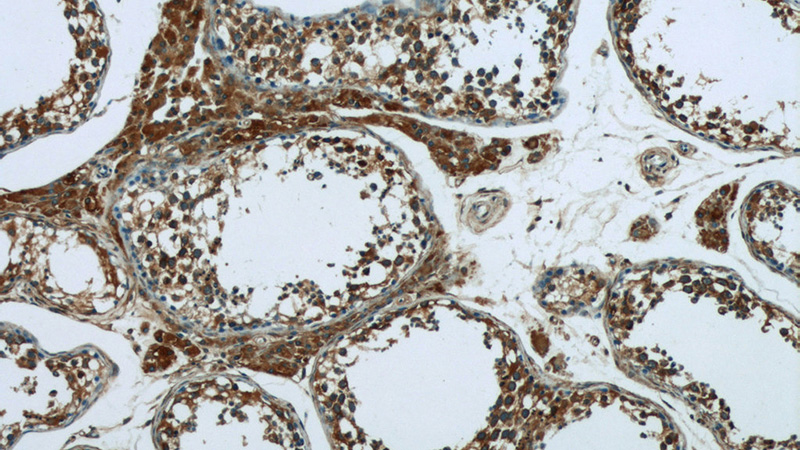
Immunohistochemistry of paraffin-embedded human testis tissue slide using Catalog No:110502(SEC10 Antibody) at dilution of 1:50 (under 10x lens)
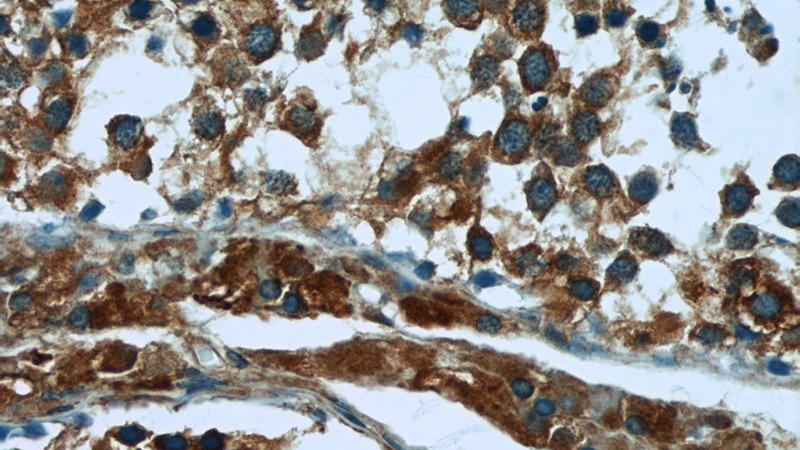
Immunohistochemistry of paraffin-embedded human testis tissue slide using Catalog No:110502(SEC10 Antibody) at dilution of 1:50 (under 40x lens)

-
Product Name
EXOC5 antibody
- Documents
-
Description
EXOC5 Rabbit Polyclonal antibody. Positive IF detected in HepG2 cells. Positive IHC detected in human testis tissue, human brain tissue. Positive IP detected in mouse brain tissue. Positive WB detected in mouse brain tissue, human adrenal gland tissue. Observed molecular weight by Western-blot: 77 kDa
-
Tested applications
ELISA, WB, IF, IP, IHC
-
Species reactivity
Human,Mouse,Rat; other species not tested.
-
Alternative names
DKFZp666H126 antibody; EXOC5 antibody; exOCyst complex component 5 antibody; HSEC10 antibody; PRO1912 antibody; SEC10 antibody; SEC10L1 antibody; SEC10P antibody
-
Isotype
Rabbit IgG
-
Preparation
This antibody was obtained by immunization of EX℃5 recombinant protein (Accession Number: NM_006544). Purification method: Antigen affinity purified.
-
Clonality
Polyclonal
-
Formulation
PBS with 0.02% sodium azide and 50% glycerol pH 7.3.
-
Storage instructions
Store at -20℃. DO NOT ALIQUOT
-
Applications
Recommended Dilution:
WB: 1:500-1:5000
IP: 1:200-1:2000
IHC: 1:20-1:200
IF: 1:10-1:100
-
Validations

mouse brain tissue were subjected to SDS PAGE followed by western blot with Catalog No:110502(SEC10 antibody) at dilution of 1:400

IP Result of anti-SEC10 (IP:Catalog No:110502, 3ug; Detection:Catalog No:110502 1:500) with mouse brain tissue lysate 4000ug.

Immunofluorescent analysis of HepG2 cells, using EXoc5 antibody Catalog No:110502 at 1:25 dilution and Rhodamine-labeled goat anti-rabbit IgG (red).
Immunohistochemistry of paraffin-embedded human testis tissue slide using Catalog No:110502(SEC10 Antibody) at dilution of 1:50 (under 10x lens)
Immunohistochemistry of paraffin-embedded human testis tissue slide using Catalog No:110502(SEC10 Antibody) at dilution of 1:50 (under 40x lens)
-
Background
EXoc5 (SEC10), a component of the exocyst complex, is a 77-kDa protein with a broad tissue distribution (PubMed: 9119050). The exocyst complex, composed of eight evolutionarily conserved subunits (SEC3, SEC5, SEC6, SEC8, SEC10, SEC15, EXO70, and EXO84), is essential for targeting exocytic vesicles to specific docking sites on the plasma membrane. The complex is also essential for the biogenesis of epithelial cell surface polarity.
-
References
- Bodemann BO, Orvedahl A, Cheng T. RalB and the exocyst mediate the cellular starvation response by direct activation of autophagosome assembly. Cell. 144(2):253-67. 2011.
- Gonzalez IM, Ackerman WE, Vandre DD, Robinson JM. Exocyst complex protein expression in the human placenta. Placenta. 35(7):442-9. 2014.
- Fogelgren B, Polgar N, Lui VH. Urothelial Defects from Targeted Inactivation of Exocyst Sec10 in Mice Cause Ureteropelvic Junction Obstructions. PloS one. 10(6):e0129346. 2015.
Related Products / Services
Please note: All products are "FOR RESEARCH USE ONLY AND ARE NOT INTENDED FOR DIAGNOSTIC OR THERAPEUTIC USE"
